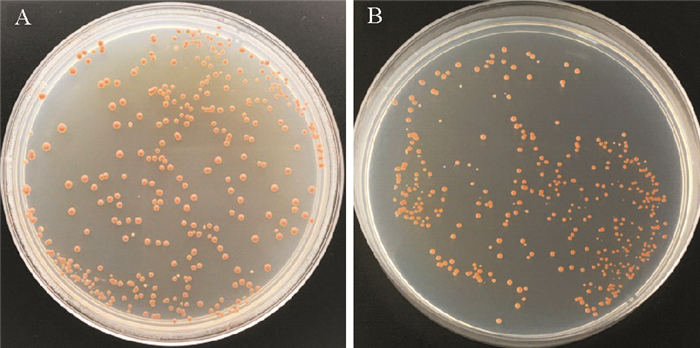
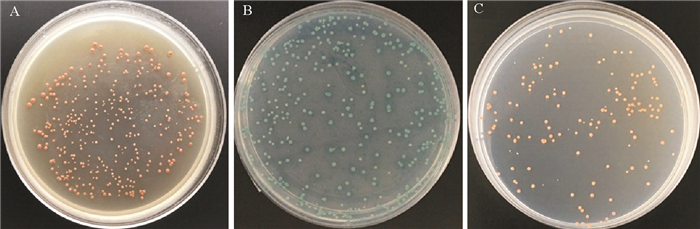
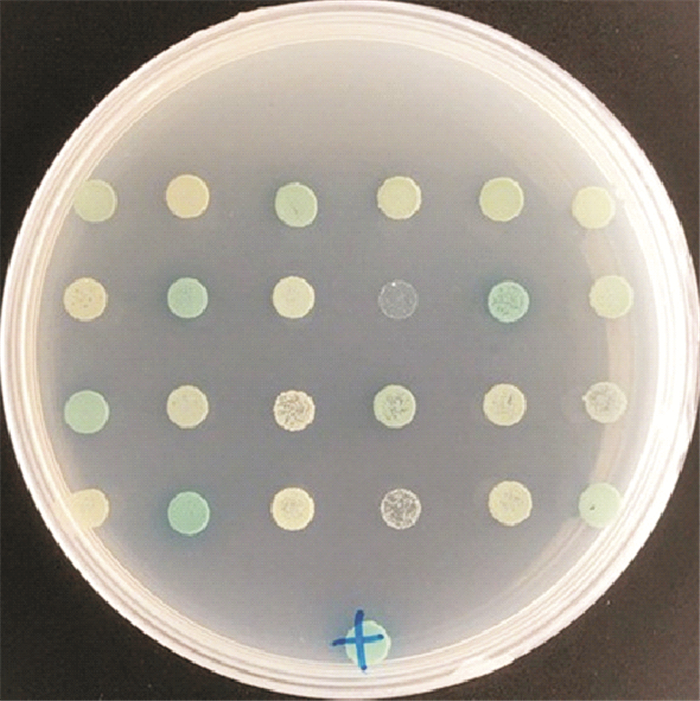
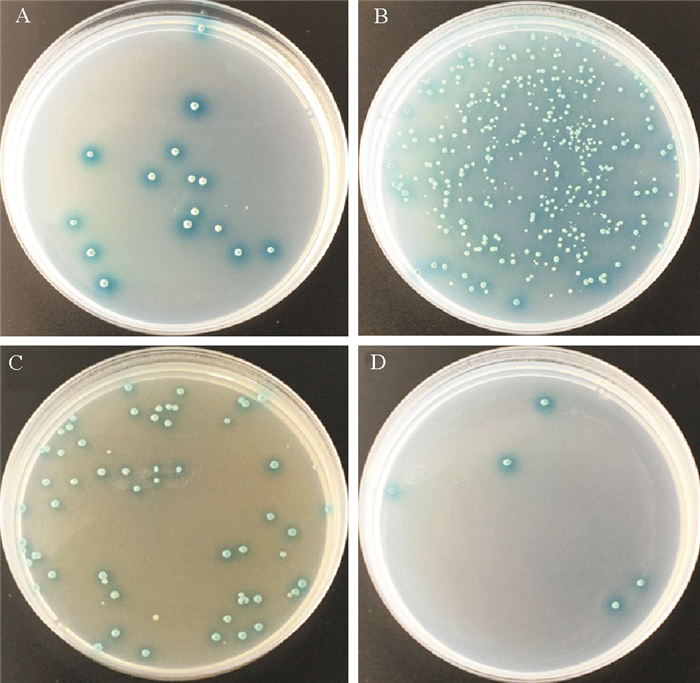

2. 海洋渔业科学与食物产出过程功能实验室,青岛海洋科学与技术国家实验室,山东 青岛 266237
FOXL2(Forkhead box L2)是叉头转录因子超家族的成员之一,在脊椎动物性别决定与分化的过程中发挥关键作用,主要参与卵巢早期发育及成体卵巢的功能维持。迄今,已在多个物种中鉴定了FOXL2基因[1-5],但较深入的研究主要集中在脊椎动物。研究发现,该基因在大多数哺乳动物的性腺中呈性别二态性表达模式。FOXL2在人性别分化前的生殖嵴细胞中表达,且在卵巢中特异性表达[1]。小鼠(Mus musculus)、鸡(Gallus gallus)、红耳龟(Trachemys scripta)的早期卵巢中检测到,FOXL2在性别决定前后表达,推测该基因参与了卵巢分化[6]。FOXL2缺失突变的XX型小鼠,其性腺表现出精巢特征,表明FOXL2对成体的卵巢具有维持功能[7]。此外,FOXL2已被确定为山羊(Capra hircus)的雌性决定基因[8]。Oshima等也发现蛙(Rana rugosa)的FOXL2在卵巢分化的早期阶段起着关键作用[9]。在罗非鱼(Oreochromis niloticus)中,FOXL2基因在卵巢分化早期到成体持续表达,说明该基因参与了鱼类性腺分化以及卵巢的功能维持[10]。
虽然在一些无脊椎动物中已经获得FOXL2基因,但关于该基因的研究相对较少。Zhang等分析了太平洋牡蛎(Crassostrea gigas)FOXL2基因在性腺等组织的表达情况,认为该基因可能是牡蛎性别决定的关键基因[11]。在栉孔扇贝(Chlamys farreri)中,FOXL2基因也呈现性别二态性表达,推测其为雌性相关基因[12],并可能参与卵巢分化[13]。Li等分析了虾夷扇贝(Patinopecten yessoensis)的精巢和卵巢转录组,认为FOXL2是虾夷扇贝性别决定/分化的关键候选基因[14]。珠母贝(Pinctada margaritifera)的研究也发现FOXL2在其性反转和性别分化过程中起着重要作用[15]。
由此推测,FOXL2很可能是跨无脊椎动物和脊椎动物类群的保守的雌性决定与分化的关键基因。在脊椎动物中,FOXL2主要通过调控芳香化酶CYP19A1的表达,决定或维持雌性性别[16-17];但已有研究显示,CYP19A1在脊索动物才出现[18],在诸如扇贝之类的无脊椎动物并不存在。可见,FOXL2性别决定的机制在脊椎动物与无脊椎动物之间可能有所不同。该基因在无脊椎动物中究竟与哪些蛋白相互作用,如何行使功能,目前尚不清晰。本研究将以虾夷扇贝为材料,应用酵母双杂交系统初步筛选与FOXL2相互作用的蛋白,为解析无脊椎动物FOXL2的性别决定机制提供思路。
1 材料与方法 1.1 实验材料实验材料二龄虾夷扇贝采自辽宁省大连市獐子岛养殖中心,取扇贝性腺组织,液氮固定后保存于-80 ℃冰箱以备提取RNA。虾夷扇贝酵母双杂交cDNA文库和E.coli DH5α由本实验室保存;酵母菌株Y2HGold和Y187购自Clonetech公司;限制性内切酶购自Takara公司;X-α-Gal、Aureobasidin A(AbA)、MatchmakerTM Gold Yeast Two-Hybrid System试剂盒和YeastmakerTM Yeast Transformation System 2试剂盒及各种酵母缺陷型培养基均购自Clontech公司。
1.2 方法 1.2.1 诱饵质粒pGBKT7-FOXL2的构建参考In-Fusion® HD Cloning Kit说明书设计虾夷扇贝FOXL2基因的PCR引物,在FOXL2基因的ORF区5’端引入一段与线性化载体pGBKT7末端同源的16个碱基序列,引物序列如下:FOXL2-F:5’-CATGGAGGCCGAATTCATGGCCTTGTCATTTTACGACTCC-3’,FOXL2-R:5’-GCAGGTCGACGGATCCTCACCTCTCTCCCCAGTACGTGTA-3’(下划线部分为线性载体同源序列);提取虾夷扇贝性腺组织RNA,以反转录的虾夷扇贝cDNA为模板,高保真DNA扩增酶扩增FOXL2基因片段,纯化PCR产物。利用EcoR Ι和BamH Ι双酶切空载体pGBKT7并纯化。将纯化后的目的基因和线性化载体pGBKT7构建In-Fusion反应体系,50 ℃孵育15 min,然后置于冰上,反应液转化E.coli DH5α,于含有卡那霉素的LB固体培养基37 ℃过夜培养。挑取单克隆,菌液PCR验证,阳性克隆提取质粒并测序。
1.2.2 诱饵蛋白毒性及自激活检测利用YeastmakerTM Yeast Transformation System 2试剂盒制备以及转化酵母感受态。将诱饵质粒pGBKT7-FOXL2、空载体pGBKT7分别转化到Y2HGold感受态细胞中,涂布于SD/-Trp,SD/-Trp/X-α-Gal固体培养基;质粒pGBKT7-53和pGADT7-T、质粒pGBKT7-Lam和pGADT7-T共转化Y2HGold感受态作为阳性对照和阴性对照,涂布于SD/-Leu/-Trp/X-α-Gal固体培养基,30 ℃培养3~5 d,观察酵母菌株的生长情况,检测诱饵蛋白对酵母菌株是否具有毒性和自激活活性。
1.2.3 虾夷扇贝酵母双杂交cDNA文库滴定实验实验室前期已构建虾夷扇贝酵母双杂交cDNA文库,将1/100,1/10 000的文库稀释液涂布于SD/-Leu固体培养基,30 ℃培养3~5 d,统计菌落个数,计算文库滴度。
1.2.4 酵母双杂交筛选FOXL2互作蛋白从SD/-Trp固体培养基挑取2~3 mm的Y2HGold[pGBKT7-FOXL2]新鲜克隆,于50 mL SD/-Trp液体培养基30 ℃过夜培养,至OD600达0.8。离心,弃上清液,4~5 mL SD/-Trp液体培养基重悬菌体并置于2 L的锥形瓶中,加入1 mL虾夷扇贝酵母双杂交cDNA文库和45 mL含有50 μg/mL卡那霉素的2×YPDA液体培养基,30 ℃、30~50 r/min培养20~24 h,离心,10 mL含有50 μg/mL卡那霉素的0.5×YPDA液体培养基重悬菌体。各取100 μL 1/10,1/100,1/1 000,1/10 000的稀释杂交菌液涂布于SD/-Trp、SD/-Leu、SD/-Leu/-Trp固体培养基,30 ℃培养3~5 d后,统计各板菌落数,计算杂交效率。剩余杂交菌液涂布于SD/-Leu/-Trp/X-α-Gal/AbA固体培养基,30 ℃培养3~5 d。挑取培养基上长出的蓝色单菌落,接种到高筛选强度的SD/-Ade/-His/-Leu/-Trp/X-α-Gal/AbA培养基上,进一步筛选出蓝色阳性克隆,提取阳性克隆酵母质粒,PCR鉴定并测序。
1.2.5 共转化验证阳性克隆酵母质粒转化E.coli DH5α,于含有氨苄青霉素的LB固体培养基进行选择培养,提取猎物质粒,分别和质粒pGBKT7-FOXL2共转化Y2HGold感受态细胞,30 ℃培养3~5 d后,观察酵母菌株的生长情况。
2 结果 2.1 诱饵质粒pGBKT7-FOXL2的构建根据虾夷扇贝FOXL2基因序列和线性化载体pGBKT7序列设计特异性引物,PCR扩增产物经1.5%琼脂糖凝胶电泳检测,目的片段大小在1 000~2 000 bp之间,与理论值(1 139 bp)一致(见图 1)。构建的诱饵质粒转化E.coli DH5α,阳性克隆进行测序。序列比对分析确定阳性克隆包含虾夷扇贝FOXL2基因的ORF框序列,重组的诱饵质粒读码框无移码突变,说明诱饵质粒pGBKT7-FOXL2构建成功。

|
( F:FOXL2基因PCR产物;M:DNA分子质量标准(DL2 000)。F: FOXL2 PCR product; M: DL2 000 DNA marker. ) 图 1 FOXL2基因PCR产物电泳图 Fig. 1 Electrophoretic result of FOXL2 PCR product |
将诱饵质粒pGBKT7-FOXL2、空载体pGBKT7分别转化Y2HGold感受态细胞,涂布于SD/-Trp固体培养基。结果显示两者菌落大小相近(见图 2),说明诱饵蛋白无毒性。将诱饵质粒pGBKT7-FOXL2转化Y2HGold感受态细胞,涂布于SD/-Trp/X-α-Gal固体培养基,结果如图 3A所示,诱饵质粒pGBKT7-FOXL2转化的酵母细胞在SD/-Trp/X-α-Gal培养基上长出单菌落但未变蓝。而阳性对照共转化质粒pGBKT7-53和pGADT7-T的酵母细胞在SD/-Leu/-Trp/X-α-Gal培养基上生长且显蓝色(见图 3B),阴性对照共转化质粒pGBKT7-Lam和pGADT7-T的酵母细胞在SD/-Leu/-Trp/X-α-Gal培养基上生长但不显蓝色(见图 3C)。这说明pGBKT7-FOXL2诱饵蛋白不能激活报告基因MEL1,诱饵蛋白无自激活活性。
|
( A:pGBKT7-FOXL2涂布SD/-Trp培养基;B:pGBKT7涂布SD/-Trp培养基。A: pGBKT7-FOXL2 on SD/-Trp medium; B: pGBKT7 on SD/-Trp medium. ) 图 2 诱饵蛋白毒性检测 Fig. 2 Testing on the toxicity of bait protein |
|
( A:pGBKT7-FOXL2涂布SD/-Trp/X-α-Gal培养基;B:阳性对照(pGBKT7-53 + pGADT7-T)涂布SD/-Leu/-Trp/X-α-Gal培养基;C:阴性对照(pGBKT7-Lam + pGADT7-T)涂布SD/-Leu/-Trp/X-α-Gal培养基。A: pGBKT7-FOXL2 on SD/-Trp/X-α-Gal medium; B: positive control (pGBKT7-53 + pGADT7-T) on SD/-Leu/-Trp/X-α-Gal medium; C: negative control (pGBKT7-Lam + pGADT7-T) on SD/-Leu/-Trp/X-α-Gal medium. ) 图 3 诱饵蛋白自激活活性检测 Fig. 3 Testing on the autoactivation of bait protein |
稀释104倍的50 μL文库稀释液涂布SD/-Leu培养基,获得约200个酵母单菌落。根据滴度计算公式:滴度=(菌落个数/涂板体积mL)×稀释倍数,计算得到文库滴度为4×107cfu/mL,大于2×107cfu/mL,说明虾夷扇贝酵母双杂交cDNA文库符合酵母双杂交的滴度要求。
2.4 FOXL2互作蛋白的筛选酵母杂交菌液涂布后,统计各培养基平板的菌落个数,经计算共筛选的二倍体克隆数为6×106,杂交效率为7.14%,符合实验要求。本研究利用酵母双杂交系统,在SD/-Leu/-Trp/X-α-Gal/AbA固体培养基上筛选出24个蓝色单菌落,进一步在SD/-Ade/-His/-Leu/-Trp/X-α-Gal/AbA培养基上筛选出17个蓝色阳性克隆(见图 4)。
|
图 4 酵母双杂交筛选阳性克隆结果图 Fig. 4 The positive clones screened by yeast two-hybrid system |
提取蓝色阳性克隆酵母质粒进行PCR鉴定(见图 5),结果显示阳性克隆均含有插入片段,片段大小主要集中在750~2 000 bp。阳性克隆酵母质粒转化E.coli DH5α,涂布于含有氨苄青霉素的培养基后,提取猎物质粒,测序鉴定。测序结果在NCBI数据库进行比对,验证出12个读码框正确的阳性克隆,共得到4种虾夷扇贝FOXL2的候选相互作用蛋白,分别是COP9信号复合体亚基5、钠/钾ATP酶β3、哺乳动物室管膜相关蛋白1和胰脂肪酶相关蛋白2(见表 1)。

|
图 5 FOXL2筛选的阳性克隆PCR鉴定结果(部分) Fig. 5 Identification of the positive clones by PCR (partial) |
|
|
表 1 虾夷扇贝FOXL2的互作蛋白信息列表 Table 1 Interacting Proteins of scallop FOXL2 |
将4种互作蛋白的猎物质粒分别和质粒pGBKT7-FOXL2共转化Y2HGold感受态细胞,涂布于SD/-Ade/-His/-Leu/-Trp/X-α-Gal/AbA固体培养基。共转化实验结果(见图 6)显示,培养基上均出现蓝色菌落,说明激活了报告基因的表达,验证结果均为阳性,表明这4种蛋白与虾夷扇贝FOXL2都可能存在相互作用。
|
图 6 4种FOXL2互作蛋白的共转化验证 Fig. 6 Cotransformation analysis between FOXL2 and the four interacting proteins |
虾夷扇贝属于软体动物门(Mollusca)、瓣鳃纲(Lamellibranchia)、珍珠贝目(Pterioida)、扇贝科(Pectenidae),是具有重要经济价值的海洋贝类。虾夷扇贝全基因组测序的完成,为我们提供了一个全新的视角去探究FOXL2在无脊椎动物中的功能。本实验室前期研究发现,与脊椎动物相似,FOXL2很可能参与虾夷扇贝的卵巢发育和维持。但FOXL2在无脊椎动物中的研究较少,对该基因的功能分析还不够深入。本研究成功构建了重组诱饵质粒pGBKT7-FOXL2,且实验表明诱饵蛋白对酵母菌株无毒,也无自激活活性,可以进行后续实验。利用酵母双杂交系统共筛选出了4种可能与虾夷扇贝FOXL2的相互作用蛋白,为研究FOXL2基因在虾夷扇贝中的功能提供了参考。
研究结果显示,COP9信号复合体亚基5(COP9 signalosome complex subunit 5,CSN5)是FOXL2的候选互作蛋白。COP9信号复合体(CSN)由8个亚基组成,在物种间较为保守[19]。CSN的主要功能是参与去Nedd化(Deneddylation)和磷酸化反应,它能使E3泛素连接酶的Cullin去Nedd化,从而调控Cullin-Ring泛素连接酶的活性。CSN5是COP9信号复合体的第五个亚基,具有催化中心并可以稳定的独立存在,对CSN起着关键作用[20]。研究发现,CSN5的对应蛋白BmJM在家蚕(Bombyx mori)生殖腺的表达水平较其它组织高,推测家蚕CSN5蛋白通过参与细胞周期相关蛋白的降解来调控细胞增殖发育过程[21]。Doronkin等发现果蝇(Drosophila melanogaster)中CSN5突变阻止Gurken蛋白在卵母细胞中的积累,说明了CSN5对卵子发生的重要性[22]。Smith等利用RNAi干扰秀丽隐杆线虫(Caenorhabditis elegans)CSN5,发现F1代线虫卵子发生缺陷,导致其性腺变小且缺少卵母细胞,由此可知CSN5对线虫卵子发生具有关键作用[23]。酵母双杂交实验初步表明CSN5与虾夷扇贝FOXL2相互作用,鉴于CSN5在细胞周期和配子发生中的重要作用,推测CSN5可能调控FOXL2蛋白的表达进而影响卵子发生过程。此外CSN能使一些转录因子磷酸化,关于CSN5与FOXL2之间的作用还有待进一步研究。
虾夷扇贝酵母双杂交结果显示FOXL2和胰脂肪酶相关蛋白(Pancreatic lipase-related protein,PLRP)具有直接的相互作用,这与之前的研究结果一致。比如,Kim等在扇贝卵巢中获得了编码PLRP的基因,RT-PCR结果显示该基因在卵巢中高表达,而在精巢中低表达,暗示PLRP在扇贝卵母细胞的成熟和卵黄发生时期的脂质代谢中发挥作用[24]。Dheilly等在太平洋牡蛎中筛选得到配子形成早期表达的雌性特异性基因,其中就包括FOXL2和PLRP[25]。以上研究结果说明FOXL2和PLRP关系密切,可能共同参与卵巢发育过程。
哺乳动物室管膜相关蛋白1(Mammalian ependymin-related protein 1,MERP1)和钠/钾ATP酶β3(Sodium/potassium-transporting ATPase subunit beta-3)是扇贝FOXL2的另两个互作蛋白。目前室管膜素相关蛋白的功能尚不清晰,但室管膜素相关蛋白在成体小鼠卵巢的体细胞中表达量较高[26],这与FOXL2主要在卵巢中表达这一现象类似,暗示MERP很可能与FOXL2有直接的相互作用。此外,已有研究发现,钠/钾ATP酶是主动跨膜转运钠钾离子的载体蛋白,具有信号传导功能,参与调控基因的表达及细胞的生长[27]。钠/钾ATP酶还可能通过脑对卵巢的激素发挥调控作用[28]。由于相关报道较少,钠/钾ATP酶与FOXL2之间到底有怎样的联系有待进一步的研究。
| [1] |
Cocquet J, Pailhoux E, Jaubert F, et al. Evolution and expression of FOXL2[J]. Journal of Medical Genetics, 2002, 39(12): 916-921. DOI:10.1136/jmg.39.12.916
(  0) 0) |
| [2] |
Nagahama Y. Molecular mechanisms of sex determination and gonadal sex differentiation in fish[J]. Fish Physiology & Biochemistry, 2005, 31(2-3): 105-109.
(  0) 0) |
| [3] |
Tu Q, Brown C T, Davidson E H, et al. Sea urchin Forkhead gene family:Phylogeny and embryonic expression[J]. Developmental Biology, 2006, 300(1): 49-62. DOI:10.1016/j.ydbio.2006.09.031
(  0) 0) |
| [4] |
Naimi A, Martinez A S, Specq M L, et al. Molecular cloning and gene expression of Cg-Foxl2 during the development and the adult gametogenetic cycle in the oyster Crassostrea gigas[J]. Comparative Biochemistry & Physiology Part B, 2009, 154(1): 134-142.
(  0) 0) |
| [5] |
Adell T, Müller W E. Isolation and characterization of five Fox (Forkhead) genes from the sponge Suberites domuncula[J]. Gene, 2004, 334(1): 35-46.
(  0) 0) |
| [6] |
Loffler K A, Zarkower D, Koopman P. Etiology of ovarian failure in blepharophimosis ptosis epicanthus inversus syndrome:FOXL2 is a conserved, early-acting gene in vertebrate ovarian development[J]. Endocrinology, 2003, 144(7): 3237-3243. DOI:10.1210/en.2002-0095
(  0) 0) |
| [7] |
Ottolenghi C, Omari S, Garcia-Ortiz J E, et al. FOXL2 is required for commitment to ovary differentiation[J]. Human Molecular Genetics, 2005, 14(14): 2053-2062. DOI:10.1093/hmg/ddi210
(  0) 0) |
| [8] |
Boulanger L, Pannetier M, Gall L, et al. FOXL2 is a female sexa-determining gene in the goat[J]. Current Biology Cb, 2014, 24(4): 404-408. DOI:10.1016/j.cub.2013.12.039
(  0) 0) |
| [9] |
Oshima Y, Uno Y, Matsuda Y, et al. Molecular cloning and gene expression of FOXL2 in the frog Rana rugosa[J]. General & Comparative Endocrinology, 2008, 159(2-3): 170-177.
(  0) 0) |
| [10] |
Wang D, Kobayashi T, Zhou L, et al. Molecular cloning and gene expression of FOXL2 in the nile tilapia, Oreochromis niloticus[J]. Biochemical & Biophysical Research Communications, 2004, 320(1): 83-89.
(  0) 0) |
| [11] |
Zhang N, Xu F, Guo X. Genomic analysis of the Pacific oyster (Crassostrea gigas) reveals possible conservation of vertebrate sex determination in a mollusc[J]. G3:Genes|Genomes|Genetics, 2014, 4(11): 2207-2217.
(  0) 0) |
| [12] |
Liu X L, Zhang Z F, Shao M Y, et al. Sexually dimorphic expression of foxl2 during gametogenesis in scallop Chlamys farreri, conserved with vertebrates[J]. Development Genes & Evolution, 2012, 222(5): 279-286.
(  0) 0) |
| [13] |
Liu X L, Li Y, Liu J G, et al. Gonadogenesis in scallop Chlamys farreri and Cf‐foxl2 expression pattern during gonadal sex differentiation[J]. Aquaculture Research, 2016, 47(5): 1605-1611. DOI:10.1111/are.12621
(  0) 0) |
| [14] |
Li Y, Zhang L, Sun Y, et al. Transcriptome sequencing and comparative analysis of ovary and testis identifies potential key sex-related genes and pathways in scallop Patinopecten yessoensis[J]. Marine Biotechnology, 2016, 18(4): 1-13.
(  0) 0) |
| [15] |
Teaniniuraitemoana V, Huvet A, Levy P, et al. Molecular signatures discriminating the male and the female sexual pathways in the pearl oyster Pinctada margaritifera[J]. Plos One, 2015, 10(3): e0122819. DOI:10.1371/journal.pone.0122819
(  0) 0) |
| [16] |
Si Y, Ding Y, He F, et al. DNA methylation level of cyp19a1a and FOXL2 gene related to their expression patterns and reproduction traits during ovary development stages of Japanese flounder (Paralichthys olivaceus)[J]. Gene, 2016, 575(2): 321-330. DOI:10.1016/j.gene.2015.09.006
(  0) 0) |
| [17] |
Hudson Q J, Smith C A, Sinclair A H. Aromatase inhibition reduces expression of FOXL2 in the embryonic chicken ovary[J]. Developmental Dynamics, 2005, 233(3): 1052-1055. DOI:10.1002/(ISSN)1097-0177
(  0) 0) |
| [18] |
Markov G V, Tavares R, Dauphinvillemant C, et al. Independent elaboration of steroid hormone signaling pathways in Metazoans[J]. Proceedings of the National Academy of Sciences of the United States of America, 2009, 106(29): 11913-11918. DOI:10.1073/pnas.0812138106
(  0) 0) |
| [19] |
Wei N, Deng X W. The COP9 signalosome[J]. Annual Review of Cell & Developmental Biology, 2003, 19(1): 261-286.
(  0) 0) |
| [20] |
Wei N, Serino G, Deng X W. The COP9 signalosome:More than a protease[J]. Trends in Biochemical Sciences, 2008, 33(12): 592-600. DOI:10.1016/j.tibs.2008.09.004
(  0) 0) |
| [21] |
许红, 姚斐, 盛清, 等. 家蚕JAB1/CSN5蛋白的基因克隆表达及亚细胞定位[J]. 蚕业科学, 2009, 35(3): 508-515. Xu H, Yao F, Sheng Q, et al. Gene cloning, expression and subcellular localization of JAB1/CSN5 protein from silkworm, Bombyx mori[J]. Science of Sericulture, 2009, 35(3): 508-515. DOI:10.3969/j.issn.0257-4799.2009.03.007 (  0) 0) |
| [22] |
Doronkin S, Djagaeva I, Beckendorf S K. CSN5/Jab1 mutations affect axis formation in the Drosophila oocyte by activating a meiotic checkpoint[J]. Development, 2002, 129(21): 5053-5064.
(  0) 0) |
| [23] |
Smith P, Leungchiu W M, Montgomery R, et al. The GLH proteins, Caenorhabditis elegans P granule components, associate with CSN-5 and KGB-1, proteins necessary for fertility, and with ZYX-1, a predicted cytoskeletal protein[J]. Developmental Biology, 2002, 251(2): 333-347. DOI:10.1006/dbio.2002.0832
(  0) 0) |
| [24] |
Kim K, Kim B, Kim H, et al. Pancreatic lipase-related protein (PY-PLRP) highly expressed in the vitellogenic ovary of the scallop, Patinopecten yessoensis[J]. Comparative Biochemistry & Physiology Part B Biochemistry & Molecular Biology, 2008, 151(1): 52-58.
(  0) 0) |
| [25] |
Dheilly N M, Lelong C, Huvet A, et al. Gametogenesis in the pacific oyster Crassostrea gigas:A microarrays-based analysis identifies sex and stage specific genes[J]. Plos One, 2012, 7(5): e36353. DOI:10.1371/journal.pone.0036353
(  0) 0) |
| [26] |
Herrera L, Ottolenghi C, Garcia-Ortiz J E, et al. Mouse ovary developmental RNA and protein markers from gene expression profiling[J]. Developmental Biology, 2005, 279(2): 271-290. DOI:10.1016/j.ydbio.2004.11.029
(  0) 0) |
| [27] |
文玉杰, 李晓玫. 钠钾ATP酶的信号转导功能新进展[J]. 生理科学进展, 2005, 36(2): 159-162. Wen Y J, Li X M. New advances in signal transduction of sodium/potassium-transporting ATPase[J]. Progress in Physiological Sciences, 2005, 36(2): 159-162. DOI:10.3321/j.issn:0559-7765.2005.02.015 (  0) 0) |
| [28] |
Castillo A R D, Battaner E, Guerra M, et al. Regional changes of brain Na+, K+-transporting adenosine triphosphatase related to ovarian function[J]. Brain Research, 1987, 416(1): 113-118.
(  0) 0) |
2. Laboratory for Marine Fisheries Science and Food Production Processes, Qingdao National Laboratory for Marine Science and Technology, Qingdao 266237, China
 2019, Vol. 49
2019, Vol. 49


